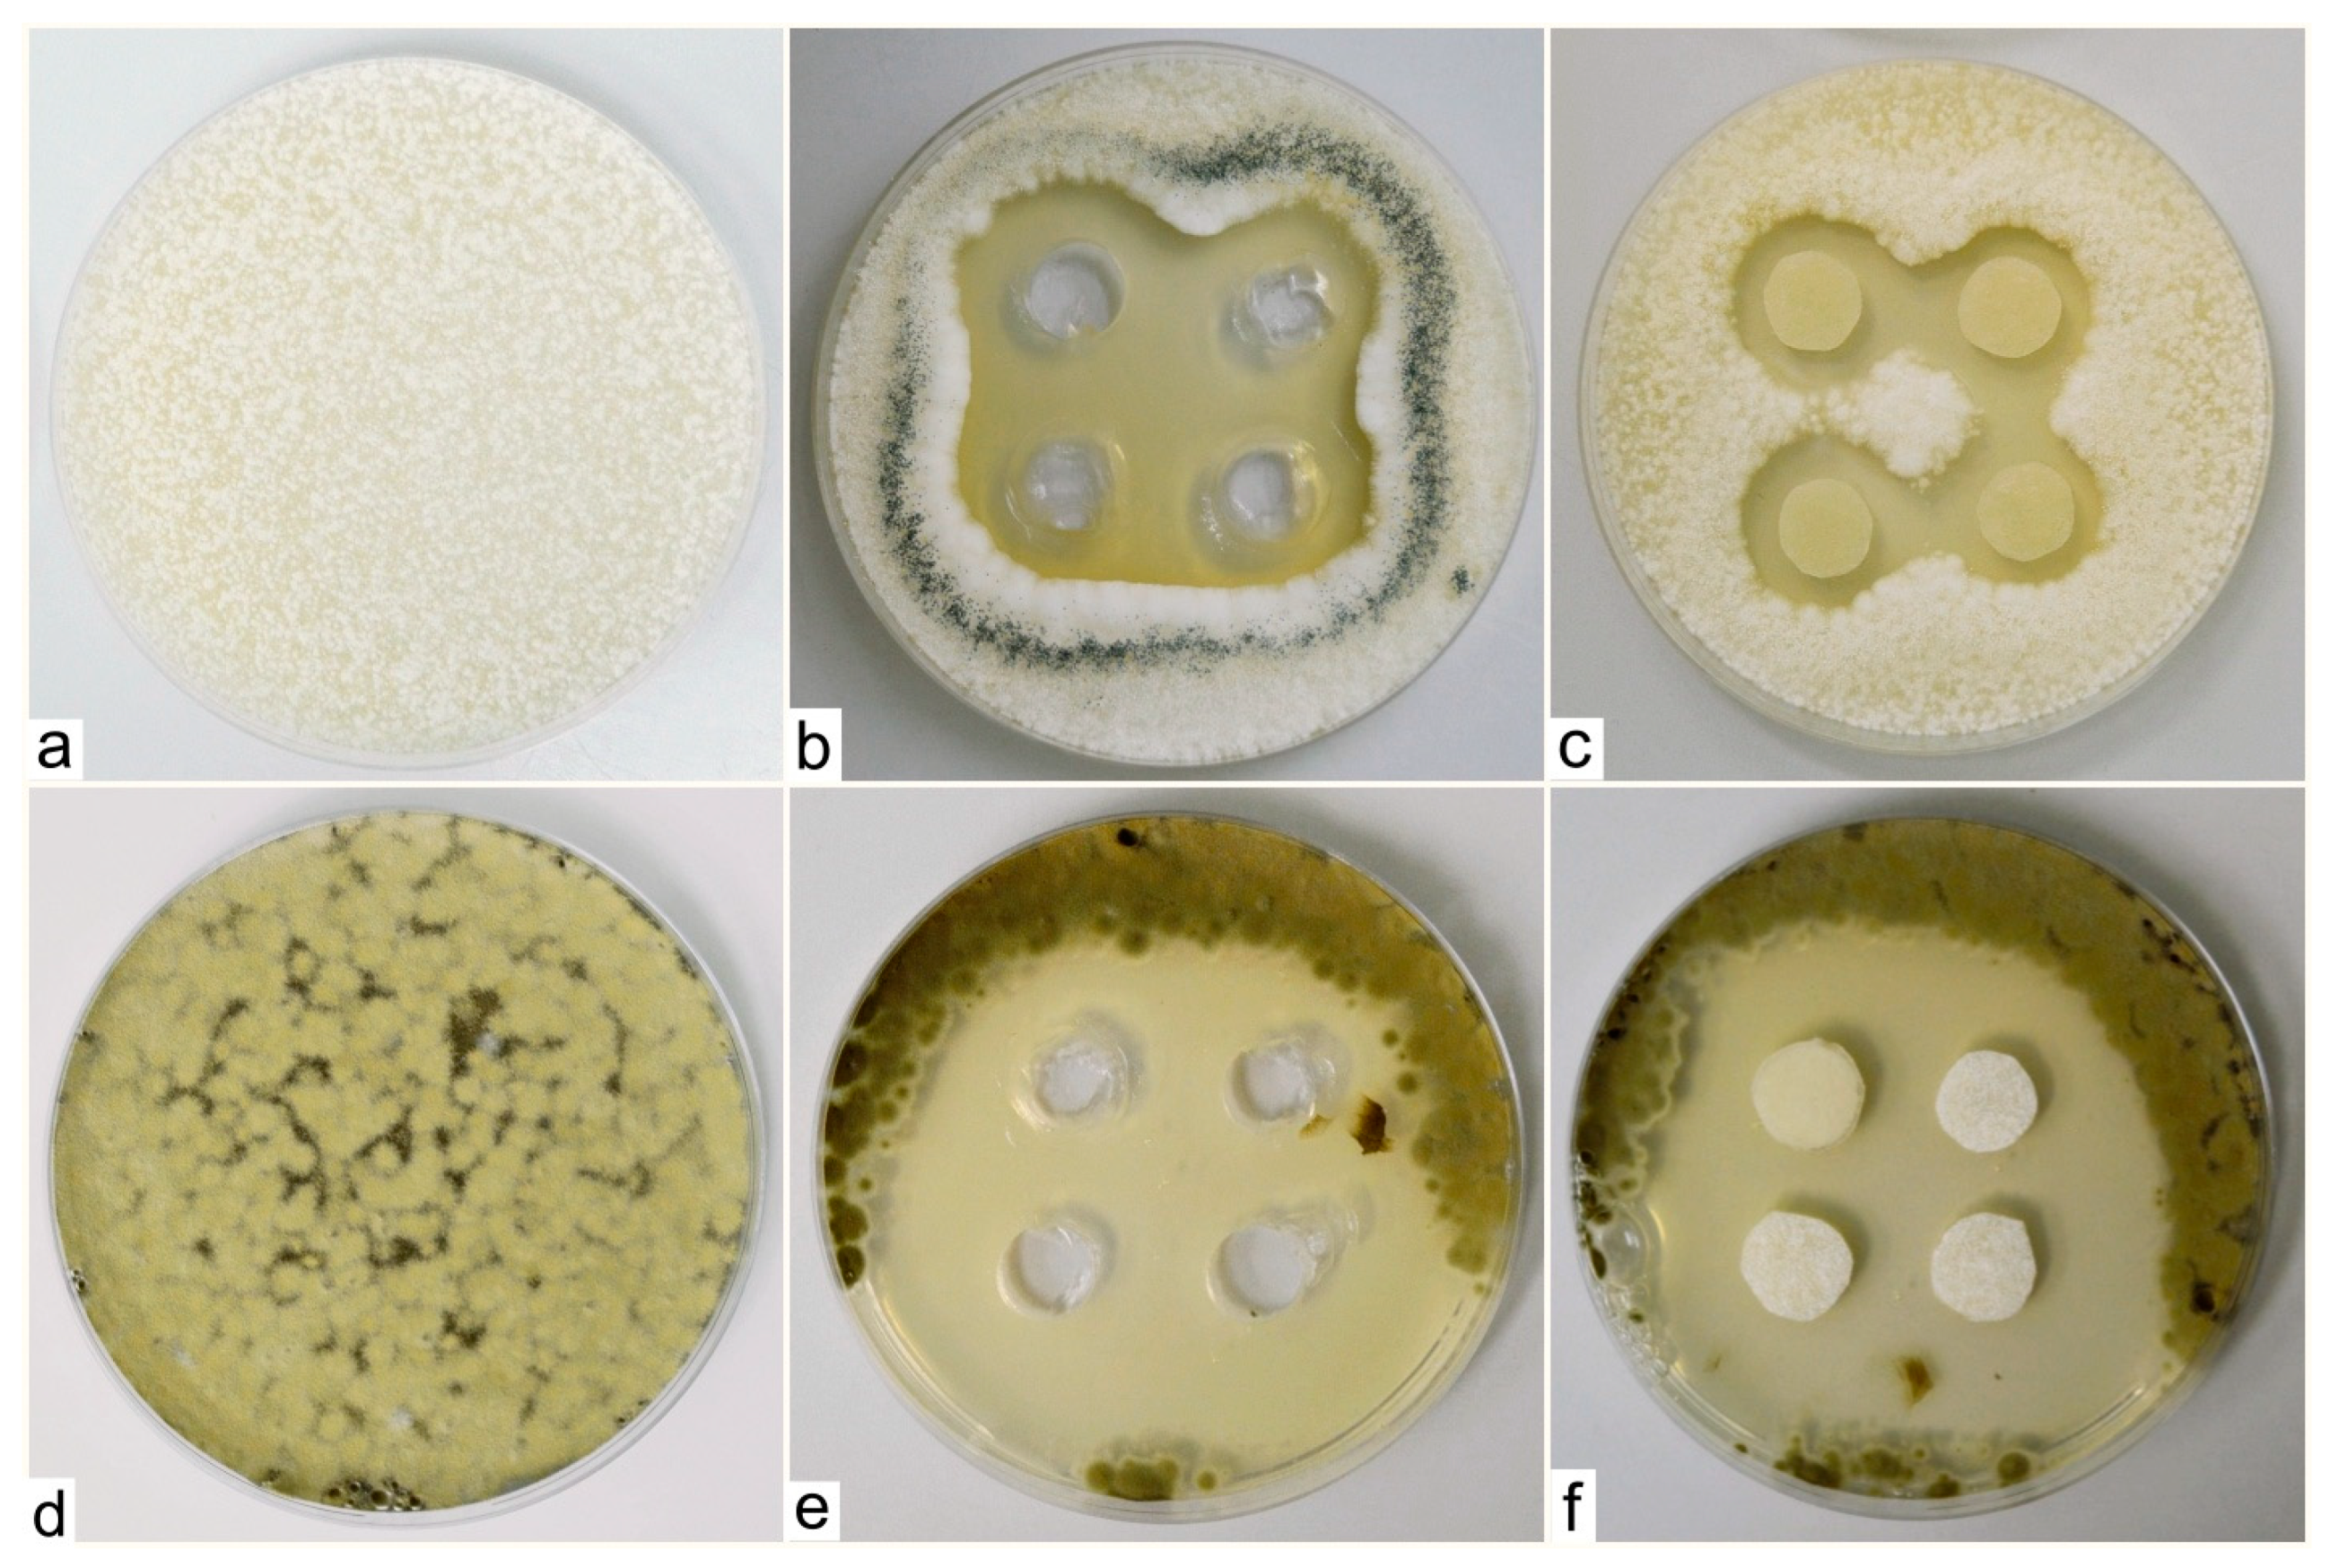
Engproc 57 00010 g003

Abstract
Two different solutions differing in their composition were tested against the following fungal phyto-pathogens: Cladosporium cladosporioides, Alternaria infectoria, Botrytis cinerea, Monilia fructigena, Aspergillus clavatus and Penicillium digitatum. The two different solutions were a fatty acid-based DPB solution and the development batch of a substance labeled M-decanocide. The tested species of fungal phyto-pathogens, namely Penicillium digitatum, Aspergillus clavatus and Cladosporium cladosporioides, grew rapidly and sporulated heavily on the agar plates with the product M-decanocide applied. In Aspergillus clavatus and Cladosporium cladosporioides cases, growth-free zones were formed around the cuts when the tested solution was applied, which confirmed its positive antifungal effect. The fungicidal effect of the tested DPB solution was not confirmed for the selected fungal phyto-pathogens.
1. Introduction
The protection of plants, especially those of agricultural importance, is crucial, because various diseases significantly reduce their quality and, consequently, their nutritional value. Some examples of such diseases are diseases caused by animal pests, such as potato tapeworm, potato aphid, snails, bugs and the so-called teddy bear, along with various rodents and so on. Plant diseases caused by viruses (so-called viroses) include the cucumber mosaic virus, plum blight, tomato bronze virus, etc. Diseases caused by bacteria (so-called bacterioses) damage, e.g., potatoes (bacterial ringworm of potatoes, brown rot of potatoes), stone fruits (bacterial spotting of stone fruits), as well as tomatoes, strawberries and other crops important for human nutrition.
Fungal diseases caused by microscopic fungi (so-called mycoses) are also very widespread. Examples include potato blight (caused by Phytophtora infestans), botrytis on vines and strawberries (Botrytis cinerea), and moniliosis (species of the genus Monilia) occurring on various stone fruits (apples, plums, pears, cherries, apricots, etc.). The so-called blacks, which are dark-to-black coatings, e.g., on beet and other host plants, are caused by species of the genera Cladosporium and Alternaria. Several fusaria (species of the genus Fusarium), as well as species of the genus Aspergillus and Penicillium, parasitize on grain. Many professional publications are reviewing pests, plant diseases and their protection [1,2,3,4].
There is a wide range of chemical preparations at disposal, which are intended not only for spraying already-damaged plants, but especially for their preventive protection against possible disease. More and more emphasis is placed on ecological protection, i.e., the use of substances on an ecological basis, within the framework of not harming the environment.
The aim of the work presented was to test the activity of two different solutions against selected phyto-fungal pathogens, the composition of which corresponds to the current “eco-friendly” requirements placed for phytosanitary agents.
2. Materials and Methods
As part of the mentioned experiment, we used the species Cladosporium cladosporioides, Alternaria infectoria, Botrytis cinerea and Monilia fructigena from the fungal pathogens of plants, which come from the collection of microorganisms at the Institute of Molecular Biology SAV s.r.i. in Bratislava, and the species Aspergillus clavatus and Penicillium digitatum isolated from grain, which come from the collection of microfungi at the Slovak Medical University in Bratislava.
The mentioned species were cultured on slant SDA (Sabouraud Dextrose Agar, Himedia, Mumbai, India) for 5 to 7 days, respectively, until visible sporulation. Twenty mL of sterile distilled water was then added after thorough shaking, and the entire volume of the spore suspension was poured into 330 mL of the prepared nutrient MEA (malt extract agar, Himedia, Mumbai, India) medium at a temperature of about 40 °C. Such an inoculated medium with each tested fungal pathogen was portioned in Petri dishes (diameter 9 cm, height of the medium after solidification 0.5 cm). We made 4 incisions for each agar plate (Figure 1) with a 10 mm corkscrew in the solid medium, into which we then applied 2–3 drops of the tested solution. The corkscrew was sterilized by a flame after every use. We also used the application of sterile Whatman filter paper discs with a diameter of 10 mm on the surface of the inoculated solid medium, onto which we dripped the tested solution until the paper was soaked (3 drops). After incubation of the inoculated systems up to 7 days at 25 °C, the presence of growth-free zones around incisions/discs with an effective antifungal mixture was observed.
Figure 1.
Scheme of Petri dishes with the cutouts (a) and filter paper discs (b) for testing the solutions.
The first tested solution was an unspecified mixture of fatty acids labeled DPB. In the experiment, we used 4 concentrations of the initial product, namely 1:10, 1:100, 1:500 and 1:1000. We used the second solution with the working designation M-decanocide only at the concentration of 1:10. Each pathogen was tested on 15 Petri dishes (3 × control sample without the test solution, 3 × tested pathogen with the solution diluted at 1:10, 3 × tested pathogen with the solution of 1:100, 3 × tested pathogen with the solution of 1:500 and 3 × tested pathogen with the solution of 1:1000).
When testing the second solution (M-decanocide), we cultured each species in 9 Petri dishes (3 × control sample without the tested solution, 3 × tested pathogen with the solution applied to sections in the agar medium, 3 × tested pathogen with the solution applied to sterile filter paper discs).
Both used solutions are under development and in the process of patenting; therefore, there is no official producer at this moment.
3. Results and Discussion
The DPB (mixture of fatty acids) solution showed a bioactive effect on the tested species of agriculturally important pests (apple borer and marbled borer). The bioactivity of these substances is not based on the classic mechanism of insecticidal products, i.e., the phytosanitary concept of pest eradication in the target agrocenosis, but on the modification of communication signals in the process of pest reproduction. Disruption of communication signals within the insect population is a method relatively well known under the name “mating disruption”. The fact that in the last 30 years, in the case of some special crops (vines, fruit orchards), this method has been used on a large scale and repeatedly, has led to selection pressure on the genetic diversity at the population level of insects. As a result, the population of pest communities in the process of fertilization within “different channels” is higher than those “having been tuned” by man 30 years ago.
Therefore, it became necessary to look for other alternatives to the “non-chemical combat”, and DPB and M-decanocide products are our answer to the mentioned requirement. Due to the fact that these are products under development, it is not possible to provide more details about their chemical composition and method of preparation.
It would be more than welcome and at the same time financially advantageous if the above-mentioned solutions, in addition to being insecticidal, also prove fungicidal effects. The species Cladosporium cladosporioides and Alternaria infectoria grew very slowly in the presence of DPB, and individual colonies appeared gradually on the culture medium, but also around the cutouts where the tested solution was applied. In addition, in close proximity to the cutouts, we noticed a relatively dense growth of the Aspergillus niger species, probably caused by air contamination. Despite the fact that we did not test the species Aspergillus niger, its growth around the cutouts was more or less identical compared to the growth of the other tested species, and more or less directly proportional to the concentration of the test solution used; we always recorded the best growth at the highest concentration of 1:10 (Figure 2).
Figure 2.
Growth of Aspergillus niger around the sections where the test solution (DPB) was applied in concentrations of 1:10 (a), 1:100 (b), 1:500 (c) and 1:1000 (d).
We also recorded the growth of mycelium of the species Penicillium digitatum and Aspergillus clavatus, not only in the control samples, but also in all Petri dishes where the test solution was applied at all four concentrations. The species Botrytis cinerea was characterized by relatively fast growth and intense sporulation. However, the inhibitory effect of the applied solution was not recorded in this case either. The growth of the species Monilia fructigena, on the other hand, was very weak and slow, both on the control plates and the plates with the tested solution.
Based on the results of the experiments so far, it is clear that no inhibition zones were formed around the cutouts in the nutrient medium with conidia of the fungal pathogen, which would mean the antifungal effect of the tested solution. Since the growth of the fungal pathogen appeared around the incisions, it indicates the un-efficacy of the tested solution as a fungicide.
The tested species of fungal phyto-pathogens, namely Penicillium digitatum, Aspergillus clavatus and Cladosporium cladosporioides, grew rapidly and sporulated heavily on agar plates with the product M-decanocide applied. In Aspergillus clavatus and Cladosporium cladosporioides cases, growth-free zones were formed around the cuts where we applied the tested solution, which confirms its positive, antifungal effect (Figure 3).
Figure 3.
Zones around the applied solution (M-decanocide) for the species Aspergillus clavatus (control sample—(a), to wells in the agar medium—(b), on sterile filter paper targets with a diameter of 1 cm—(c)) and Cladosporium cladosporioides (control sample—(d), to wells in agar medium—(e), on sterile filter paper targets with a diameter of 1 cm—(f)).
The species Monilia fructigena, Alternaria infectoria and Botrytis cinerea grew very slowly and sporulated poorly on the agar plates, thus, the efficacy of the used solution against them could not be clearly confirmed.
The occurrence of phytopathogenic fungi, which belong to different species such as Alternaria, Aspergillus, Cladosporium, Fusarium, Penicillium and others, represents a high risk to agricultural production but also human health due to the production of mycotoxins [5,6]. The species Alternaria infectoria is known for wheat infection, while Botrytis cinerea has a wide host range, affecting various crops, vegetables and fruits [7,8]. The species Cladosporium cladospoioides often cause the rotting of grapes and strawberries [9]. Monilia fructigena is a widespread phytopatogen that causes brown rot in fruits such as apples, cheries, peaches, apricot and others [10]. Penicillium digitatum often spreads on citrus fruits and thus causes losses in harvest due to infection [11]. Aspergillus clavatus is occasionaly pathogenic and can cause a disease in humans and other mammals [12]. It often occurs in soils with cultivated potatoes, cotton, sugar canes, etc., but can be also isolated from grapes or various crops, and thus represents a high risk due to the production of mycootxins [13,14].
Many pathogenic fungi are resistant to common fungicides, so there is a need for the development of new, more efficient solutions.
4. Conclusions
The fungicidal effect of the tested DPB solution was not confirmed for the selected fungal phyto-pathogens Cladosporium cladosporioides, Alternaria infectoria, Penicillium digitatum, Aspergillus clavatus, Botrytis cinerea and Monilia fructigena. The inhibitory effect of the M-decanocide solution was confirmed for the species Aspergillus clavatus and Cladosporium cladosporioides.
Author Contributions
Conceptualization, A.Š. and B.G.; methodology, A.Š. and E.P.; writing—original draft preparation, A.Š.; writing—review and editing, B.G., S.N. and E.P.; fungi preparation, D.P.; visualization, S.N. All authors have read and agreed to the published version of the manuscript.
Funding
This research received no external funding.
Institutional Review Board Statement
Not applicable.
Informed Consent Statement
Not applicable.
Data Availability Statement
All data supporting the findings in this manuscript are available upon request.
Conflicts of Interest
The authors declare no conflict of interest.
References
- Lohrer, T. Pests and Plant Disease–Pictorial Atlas, 1st ed.; Esence: Prague, Czech Republic, 2021; p. 384. (In Czech) [Google Scholar]
- Matlák, J. Year-Round Protection of Garden Crops, 1st ed.; Juraj Matlák: Bratislava, Slovakia, 2022; p. 102. (In Slovak) [Google Scholar]
- Matlák, J. Atlas of Diseases and Pests of Fruit Crops and Vines, 1st ed.; Juraj Matlák: Bratislava, Slovakia, 2023; p. 68. (In Slovak) [Google Scholar]
- Matušíková, S.; Cagáň, Ľ. Protection of Fruit Plants against Diseases, 1st ed.; Plat4MBooks: Bratislava, Slovakia, 2019; p. 264. (In Slovak) [Google Scholar]
- Tournas, V.H.; Katsoudas, E. Mould and yeast flora in fresh berries, grapes and citrus fruits. Int. J. Food Microbiol. 2005, 105, 11–17. [Google Scholar] [CrossRef] [PubMed]
- Tancinová, D.; Barboráková, Z.; Mašková, Z.; Mrvová, M.; Medo, J.; Golian, M.; Štefániková, J.; Árvay, J. In vitro antifungal activity of essential oils (family lamiaceae) against cladosporium sp. Strains–postharvest pathogens of fruits. J. Microbiol. Biotechnol. Food Sci. 2023, 13, 1–6. [Google Scholar] [CrossRef]
- Oviendo, M.S.; Sturm, M.E.; Reynoso, M.M.; Chulze, S.N.; Ramirez, M.L. Toxigenic profile and AFLP variability of Alternaria alternata and Alternaria infectoria occurring on wheat. Medical. Braz. J. Microbiol. 2013, 44, 447–455. [Google Scholar] [CrossRef] [PubMed]
- Filinger, S.; Elad, Y. Botrytis—The Fungus, the Pathogen and Its Management in Agricultural Systems; Springer: Cham, Switzerland, 2016; p. 486. [Google Scholar]
- Latorre, B.A.; Briceño, E.X.; Torres, R. Increase in Cladosporium spp. populations and rot of wine grapes associated with leaf removal. Crop Prot. 2011, 1, 52–56. [Google Scholar] [CrossRef]
- Liu, Z.; Bai, H.; Yang, H.; Tang, S.; Wei, M.; Huang, X.; Li, Y. Biological characteristics of Monilia fructigena as pathogen of brown rot in sweet cherry. Int. J. Fruit Sci. 2012, 29, 423–427. [Google Scholar]
- Papoutsis, K.; Mathioudakis, M.M.; Hasperué, J.H.; Ziogas, V. Non-chemical treatments for preventing the postharvest fungal rotting of citrus caused by Penicillium digitatum (green mold) and Penicillium italicum (blue mold). Trends Food Sci. Technol. 2019, 89, 479–491. [Google Scholar] [CrossRef]
- Razzaghi-Abyaneh, M.; Rai, M. Introductory Chapter: The Genus Aspergillus-Pathogenicity, Mycotoxin Production and Industrial Applications. In The Genus Aspergillus-Pathogenicity, Mycotoxin Production and Industrial Applications; IntechOpen: London, UK, 2022; pp. 1–4. [Google Scholar] [CrossRef]
- Felšöciová, S.; Tančinová, D.; Rybárik, Ľ.; Mašková, Z. Mycobiota of slovak wine grapes with emphasis on Aspergillus and Penicillium species in the south Slovak wine region. Potravinarstvo 2017, 11, 496–502. [Google Scholar] [CrossRef] [PubMed]
- Domsch, K.H.; Anderson, T.H.; Gams, W. Compendium of Soil Fungi, 1st ed.; Academic Press: London, UK, 1980; pp. 86–88. [Google Scholar]
Disclaimer/Publisher’s Note: The statements, opinions and data contained in all publications are solely those of the individual author(s) and contributor(s) and not of MDPI and/or the editor(s). MDPI and/or the editor(s) disclaim responsibility for any injury to people or property resulting from any ideas, methods, instructions or products referred to in the content. |
© 2023 by the authors. Licensee MDPI, Basel, Switzerland. This article is an open access article distributed under the terms and conditions of the Creative Commons Attribution (CC BY) license (https://creativecommons.org/licenses/by/4.0/).